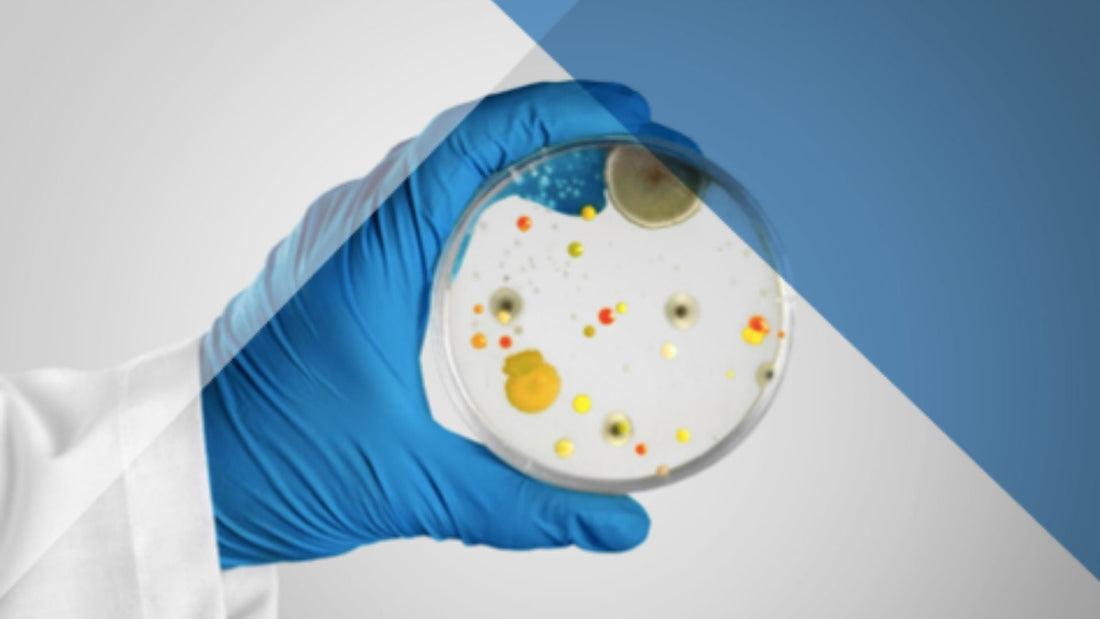

Microbiota desequilibrada y imposibilidad de perder grasa, ¿es verídica esa relación?
Aunque nos queda muchísimo por saber acerca de la Microbiota Humana debemos saber que a día de hoy hay diversos proyectos internacionales que desde aproximadamente 2008 estudian la relación entre la microbiota intestinal y las enfermedades.
Human Microbiome Project, My New Gut o MetaHIT son solo algunos de ellos, y entre sus proyectos están el estudio del eje intestino-cerebro, las redes troficas de estos microorganismos o la relación entre las enfermedades metabólicas y las bacterias que habitan en nuestro cuerpo.
En el intestino albergamos aproximadamente unos 6 o 9 filos bacterianos, de los cuales tenemos 160 especies diferentes… ¿Y sabes qué? Tenemos un total de 100 billones de bacterias aproximadamente cada uno de nosotros, y que suman un total de 600.000 genes diferentes (microbioma). ¿Eso que significa? Que somos seres HOLOBIONTES: entidades formadas por la asociación de diferentes especies que dan lugar a unidades ecológicas; y es que tenemos un poquito más de bacterias que células humanas en el intestino delgado, de hecho se trata d una relación de 1/1,3. ¿Sorprendente, verdad?
Su influencia es tal, que diversos grupos científicos han mostrado un especial interés en el estudio de este nicho ecológico que habita en nuestro interior, pues la expresión de sus genes, sus metabolitos (productos de su metabolismo) y la relación con nuestro sistema inmune influye directamente en nuestro estado de salud o enfermedad.
Bien Maria, pero explícame… ¿Que son estos “filos”? La filogenia bacteriana(phylum) es una clasificación taxonomica de los microorganismos – también denominado tronco o tipo o tipo de organización – que nos ayuda a dividir por linages a las bacterias que comentabamos antes. Estos filos son grandes grupos que dividimos en Firmicutens, Bacteroides, Actinobacteria, Proteobacteria, Verrucomicrobia y Fuseobacteria y que están presentes en todos los seres humanos.
Un 50% de las bacterias (pues son los microorganismos que más abundantes son en nuestro intestino junto a virus, hongos y parásitos) son compartidas entre los seres humanos, y sabemos que a pesar de que cada persona tenga una composición diferente, algunos filos y especies sí se comparten.
MetaHIT descubrió que un desajuste entre el ratio Firmicutens/Bacteroidetes (una disbiosis) aumenta hasta un 250% la superficie de absorción y extracción energética de los alimentos en el intestino delgado, y este patrón se observa en personas con obesidad, resistencia a la insulina y sobrepeso. ¿Eso que significa? Que esta persona absorbe mucha más cantidad de kcal que una persona sana.
Además, el consumo de alcohol, el abuso de bollería, azúcares, grasas trans o el abuso de fármacos, provoca a la vez más disbiosis y permeabilidad intestinal, lo que conlleva a un aumento de la translocación de LPS en sangre, resistencia a la insulina, hiperinsulinemia… y por lo tanto una peor oxidación de la grasa y mayor riesgo metabólico.
¿Que síntomas podría sentir una persona con este tipo de disbiosis?
- Mala recuperación muscular
- Incapacidad para bajar de peso
- Fatiga y cansancio
- Gases y hinchazón después de comer
- Retortijones abdominales
- Diarrea o estreñimiento
- Incapacidad de concentración
- Ganas de comer azúcar
- Problemas de hambre/saciedad (grelina y leptina)
¿Tiene solución?
Sí, sin duda, con la dieta, la alimentación y la fitoterapia podemos modular la microbiota. Además gracias a la invención de técnicas especializadas de laboratorio como el Shotgun Metagenomics o la secuenciación por 16S (PCR) estos grandes proyectos de los que hablamos han conseguido crear grandes bases de datos con muchísima información para ayudar a los profesionales de la salud a conocer y mejorar la biodiversidad del microbioma.
¿Como puedo hacerme las pruebas?
Tenemos diferentes pruebas para investigar la composición bacteriana de cada individuo, pero siempre es necesario la valoración de un experto formado en el área para la interpretación y la posterior terapia de modulación de la microbiota.
Para consultas con el equipo de salud integrativa y mejorar tus digestiones puedes solicitar tu cita aquí.
“Las enfermedades no nos llegan de la nada, se desarrollan a partir de pequeños pecados diarios contra la Naturaleza. Cuando se hayan acumulado suficientes, las enfermedades apareceran de repente” – Hipócrates